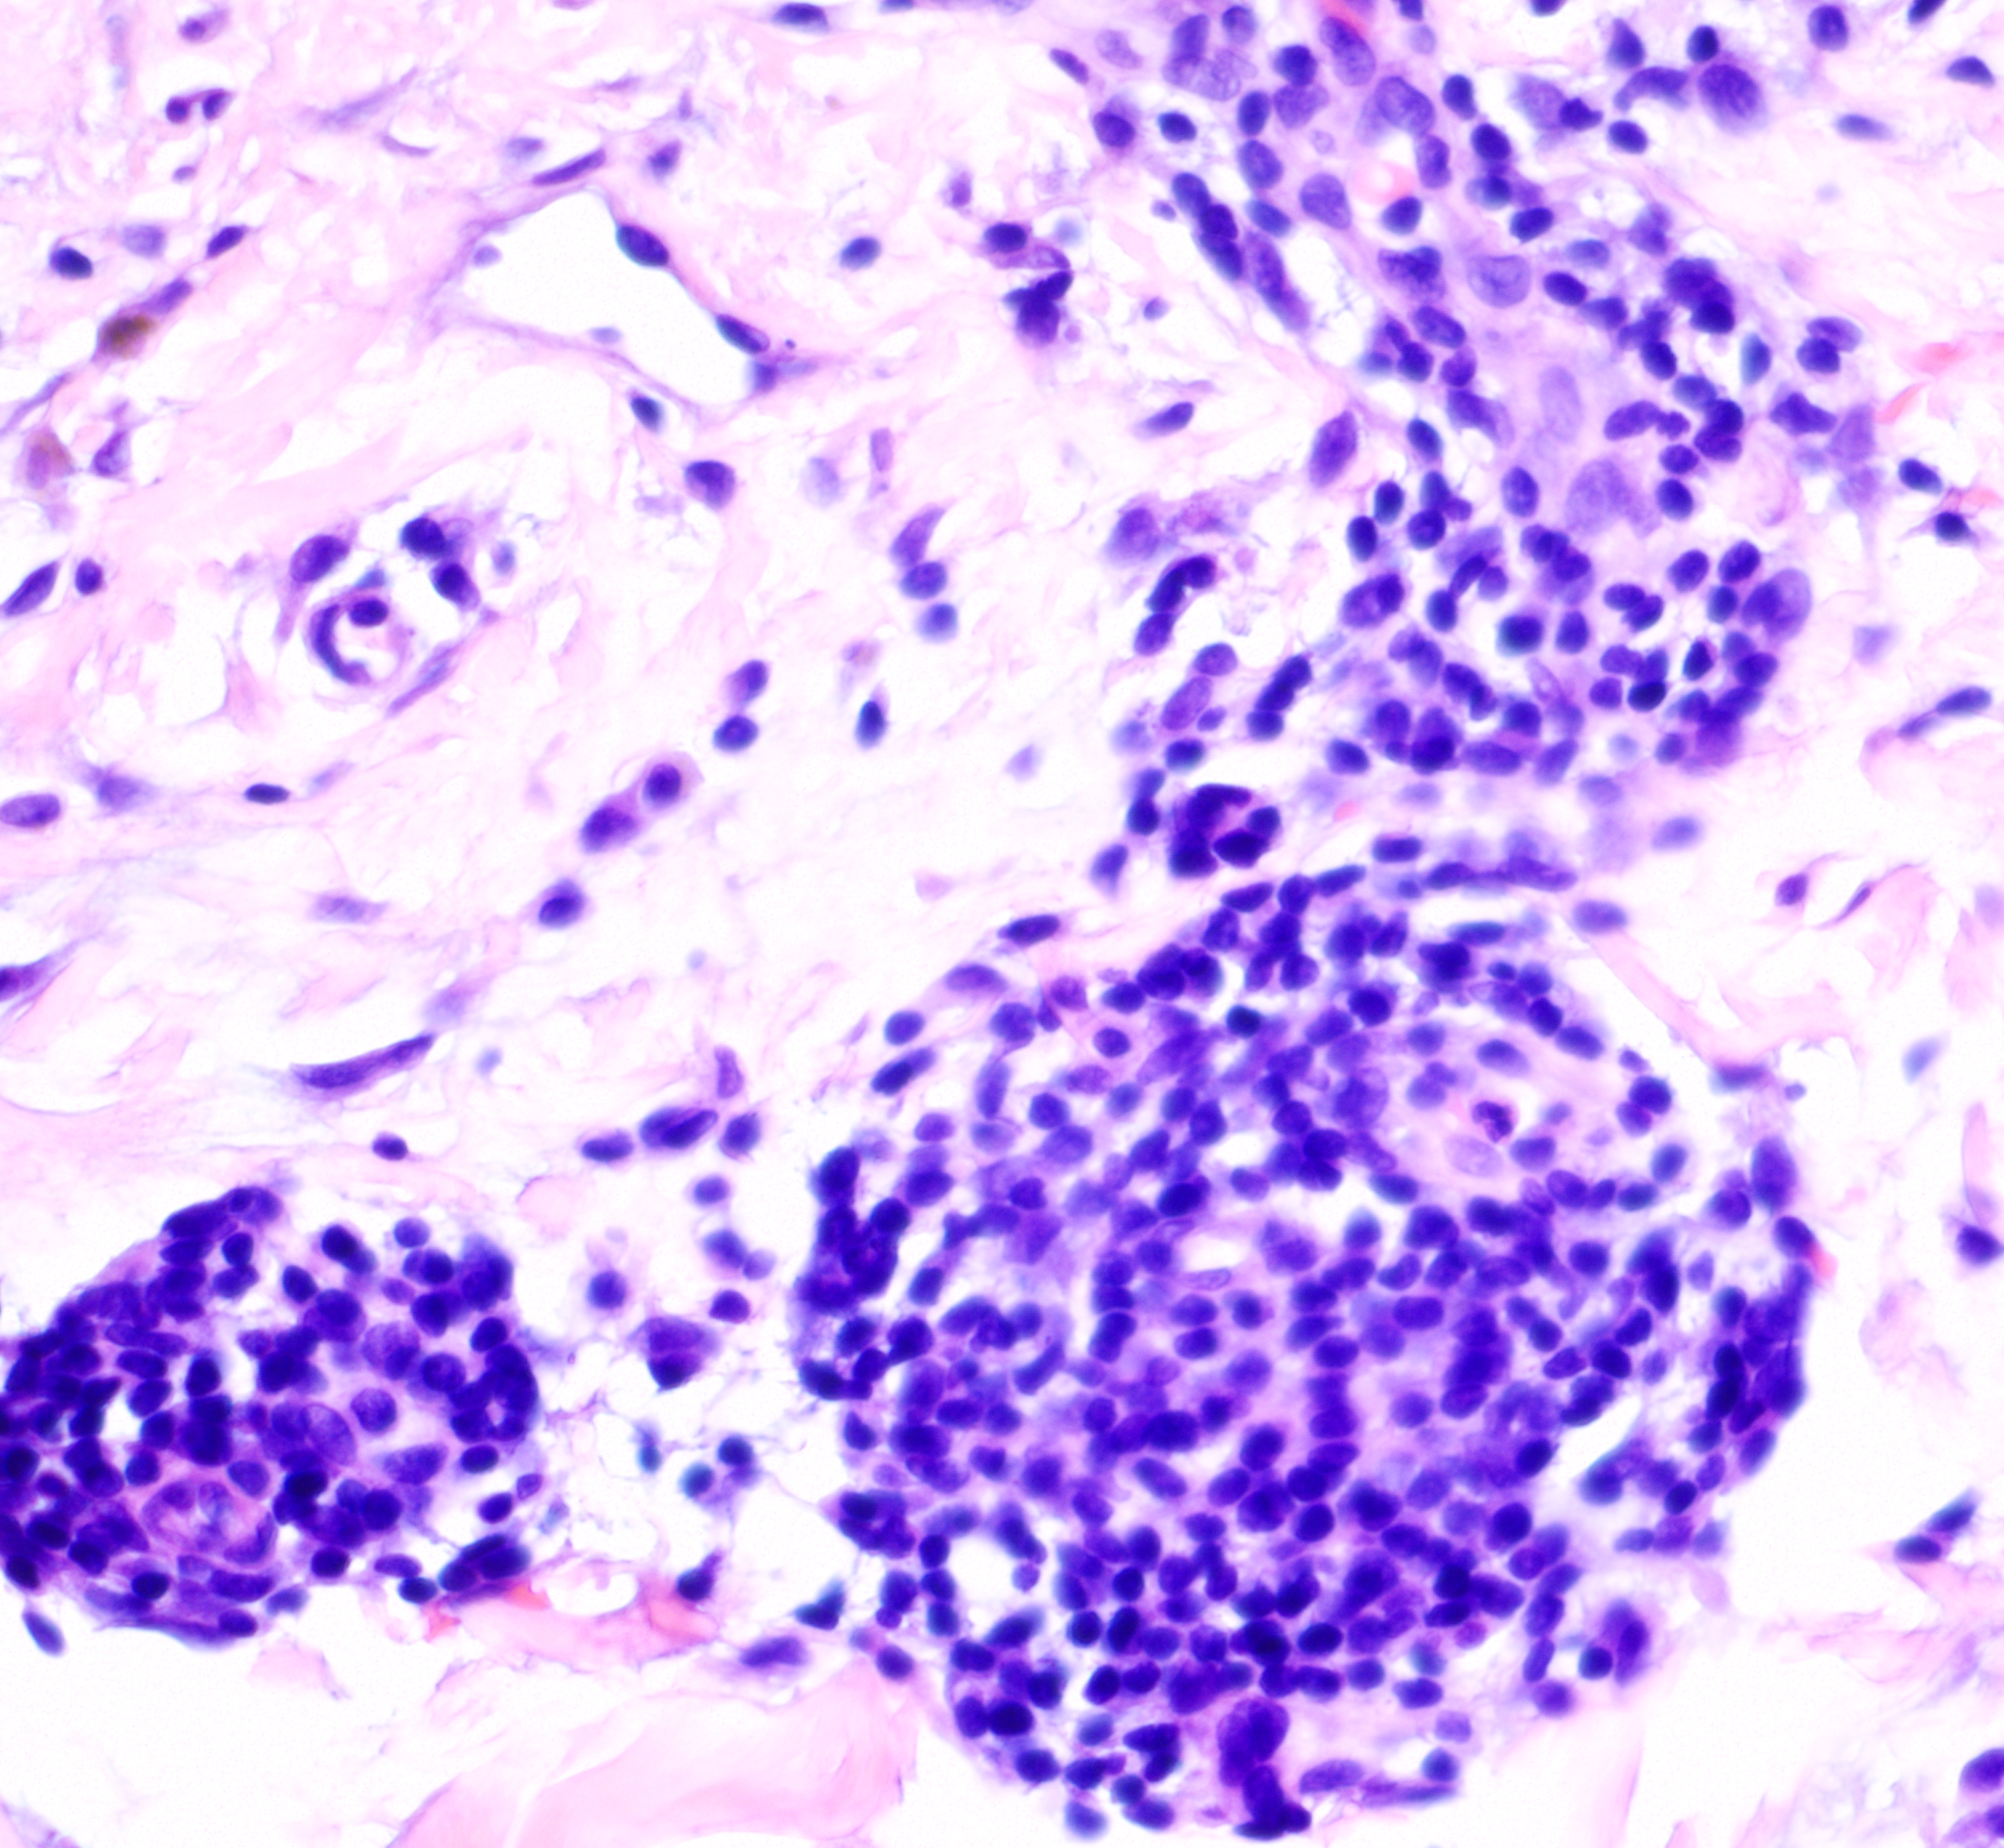
picture-5

Case Number : Case 4631 Posted By: Admin_Dermpath
Please read the clinical history and view the images by clicking on them before you proffer your diagnosis.
Submitted Date :
47-year-old Caucasian woman with erythematous macules, patches, and keratotic plaques on neck and upper chest

Join the conversation
You can post now and register later. If you have an account, sign in now to post with your account.